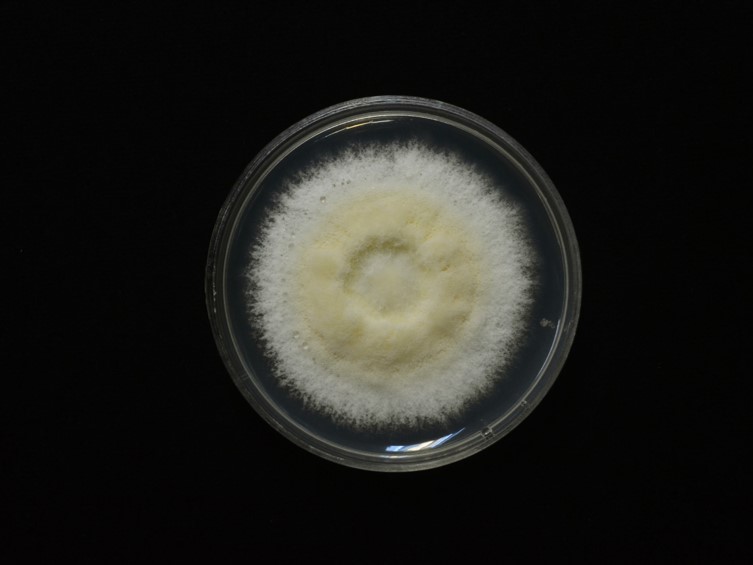

Holotype:
REPUBLIC OF KOREA, Kangwon-do, Chiag Mountain, 14 Jul. 1994, leg. J.M. Sung, holotype BPI 880997, ex-type living culture ARSEF 4850.
Habitat:
Leaf litters.
Host:
Adult of leafhoppers, ant queen, beetle adult, cicada adult, click beetle, coleoptera larva, earwigs, grasshopper eggs, lepidoptera larva, longhorn beetle, stink bug, wasp and weevil bug.
Description:
 Stroma with slightly rhizoid mycelia covering and arising from the host, on the leaf litter, solitary, simple, slightly curved, cylindrical with rounded apices, 27 mm long, 1.5 mm wide. Stipe cylindrical, yellowish white to deep yellow. Fertile head on the upper part of stroma, cylindrical with rounded apices, yellowish white to butter yellow, 10 × 2 mm.
Stroma with slightly rhizoid mycelia covering and arising from the host, on the leaf litter, solitary, simple, slightly curved, cylindrical with rounded apices, 27 mm long, 1.5 mm wide. Stipe cylindrical, yellowish white to deep yellow. Fertile head on the upper part of stroma, cylindrical with rounded apices, yellowish white to butter yellow, 10 × 2 mm.  Perithecia semi-immersed and crowded at the apex of the stroma, ovoid, 300-630 × 130-378 μm.
Perithecia semi-immersed and crowded at the apex of the stroma, ovoid, 300-630 × 130-378 μm.  Asci hyaline, cylindrical, capitate, 268-513 × 3-5 μm. Asci-caps hyaline, rounded, 2-3 × 3-5 μm.
Asci hyaline, cylindrical, capitate, 268-513 × 3-5 μm. Asci-caps hyaline, rounded, 2-3 × 3-5 μm.  Ascospores hyaline, filiform, multi-septate, breaking down into 64 part-spores, 228-455 × 1 μm. Partspores hyaline, cylindrical, 3-12 × 1 μm. Vegetative hyphae hyaline, septate, branced, smooth-walled, occasionally jagged wall. Phialides hyaline, solitary, smooth-walled, ampulliform, globose, obpyriform, 1.5-6 × 1.5-4 μm. Conidia hyaline, walls smooth, broadly ellipsoid, oblong, obovoid, 1.5-6 × 1-3 μm.
Ascospores hyaline, filiform, multi-septate, breaking down into 64 part-spores, 228-455 × 1 μm. Partspores hyaline, cylindrical, 3-12 × 1 μm. Vegetative hyphae hyaline, septate, branced, smooth-walled, occasionally jagged wall. Phialides hyaline, solitary, smooth-walled, ampulliform, globose, obpyriform, 1.5-6 × 1.5-4 μm. Conidia hyaline, walls smooth, broadly ellipsoid, oblong, obovoid, 1.5-6 × 1-3 μm.
Culture characteristics:
Colony on PDA dense, floccose, velutinous, closely appressed and slightly convex to the agar surface, greenish white in the middle, margin white, sporulation starts at 10 d after inoculation, 25−26 mm diam in 10 d, 50−52 diam in 20 d.
Colony on PDA dense, floccose, velutinous, closely appressed and slightly convex to the agar surface, greenish white in the middle, margin white, sporulation starts at 10 d after inoculation, 25−26 mm diam in 10 d, 50−52 diam in 20 d.
Reference:
Ariyawansa HA, Hyde KD, Jayasiri SC, et al. (2015). Fungal diversity notes 111–252—taxonomic and phylogenetic contributions to fungal taxa. Fungal Diversity 75:27–274.
DOI: https://doi.org/10.3852/10-302Khonsanit A, Luangsa-ard JJ, Thanakitpipattana D, et al. (2020). Cryptic diversity of the genus Beauveria with a new species from Thailand. Mycological Progress 19: 291–315.
Species |
Strain |
Compound |
Pubchem CID |
Biological activity |
Reference |
|---|
|
Strain |
Bloc | ITS | RPB1 | RPB2 | TEF1 |
|---|---|---|---|---|---|
| ARESF 4384 | HQ880716 | AY532026 | HQ880857 | HQ880929 | AY531935 |
| ARESF 4474 | HQ880717 | AY531936 | HQ880858 | HQ880930 | AY531936 |
| ARESF 4850 | HQ880718 | AY531936 | HQ880859 | HQ880931 | AY531937 |
| BCC 13243 | MN401509 | MN401629 | MN401553 | - | MN401455 |
| BCC 14510 | MN401544 | MN401674 | MN401599 | - | MN401502 |
| BCC 24977 | MN401513 | MN401633 | MN401557 | - | MN401459 |
| BCC 30900 | MN401510 | MN401630 | MN401554 | - | MN401456 |
| BCC 76548 | - | - | MN401600 | - | |
| BCC 84547 | MN401514 | - | MN401558 | - | MN401460 |
| BCC 84548 | MN401515 | MN401676 | MN401559 | - | MN401461 |